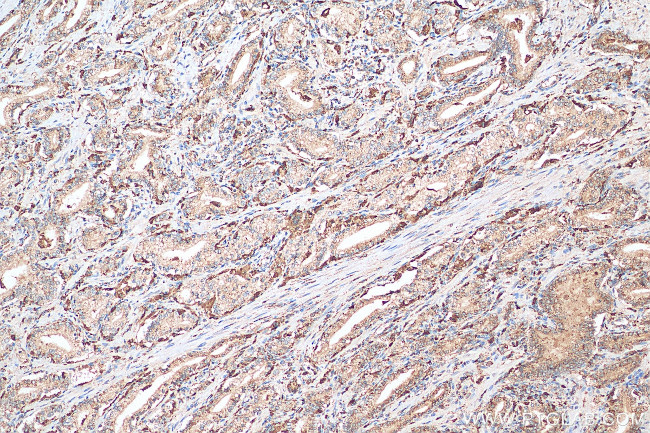
PSAP Antibody in Immunohistochemistry (Paraffin) (IHC (P))
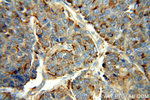
PSAP Antibody in Immunohistochemistry (Paraffin) (IHC (P))

Search
Proteintech
PSAP Polyclonal Antibody
{{$productOrderCtrl.translations['antibody.pdp.commerceCard.promotion.promotions']}}
{{$productOrderCtrl.translations['antibody.pdp.commerceCard.promotion.viewpromo']}}
{{$productOrderCtrl.translations['antibody.pdp.commerceCard.promotion.promocode']}}: {{promo.promoCode}} {{promo.promoTitle}} {{promo.promoDescription}}. {{$productOrderCtrl.translations['antibody.pdp.commerceCard.promotion.learnmore']}}
产品信息
18397-1-AP
种属反应
宿主/亚型
分类
类型
抗原
偶联物
形式
浓度
规格
纯化类型
保存液
内含物
保存条件
运输条件
产品详细信息
This antibody should recognize saposin B.
Immunogen sequence: DVCQDCIQM VTDIQTAVRT NSTFVQALVE HVKEECDRLG PGMADICKNY ISQYSEIAIQ MMMHMQPKEI CALVGFCDEV (196-274 aa encoded by BC001503)
靶标信息
PSAP is a highly conserved glycoprotein which is a precursor for 4 cleavage products: saposins A, B, C, and D. Each domain of the precursor protein is approximately 80 amino acid residues long with nearly identical placement of cysteine residues and glycosylation sites. Saposins A-D localize primarily to the lysosomal compartment where they facilitate the catabolism of glycosphingolipids with short oligosaccharide groups. The precursor protein exists both as a secretory protein and as an integral membrane protein and has neurotrophic activities.
仅用于科研。不用于诊断过程。未经明确授权不得转售。
篇参考文献 (0)
生物信息学
蛋白别名: co-beta glucosidase precursor; precursor of saposins; Proactivator polypeptide; Prosaposin; PSAP; saposin-A; saposin-B; saposin-C; saposin-D; sphingolipid activator protein-1; sphingolipid activator protein-2; unnamed protein product
基因别名: GLBA; PARK24; PSAP; PSAPD; SAP1; SAP2
UniProt ID: (Human) P07602
Entrez Gene ID: (Human) 5660